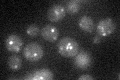
YOR081C
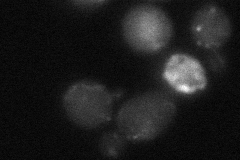
YOR081C
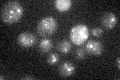
YOR081C

View description
Bifunction enzyme with triacylglycerol lipase and lysophosphatidic acid acyltransferase activity; involved in triacylglycerol mobilization; localizes to lipid particles; potential Cdc28p substrate
Localization:
Intensity:
Fold change:
Significance:
-
C’ GFP library in SD
punctate21.23 -
N' NOP1pr-GFP in SD

punctate56.309 -
N' TEF2pr-mCherry in SD

punctate48.5338 -
N' NATIVEpr-GFP in SD

punctate28.1372 -
N' TEF2pr-VC and Cyto-VN in SD
below threshold24.6845 -
C’ GFP library in SD+DTT

punctate23.511.1No -
C’ GFP library in SD+H2O2

punctate25.81.21No -
C’ GFP library in Starvation Media
punctate20.590.96No -
C’ GFP library on the background of Pup2-DaMP

punctate -
C’ GFP library on the background of CCT mutant

punctate20.54510.967544No
